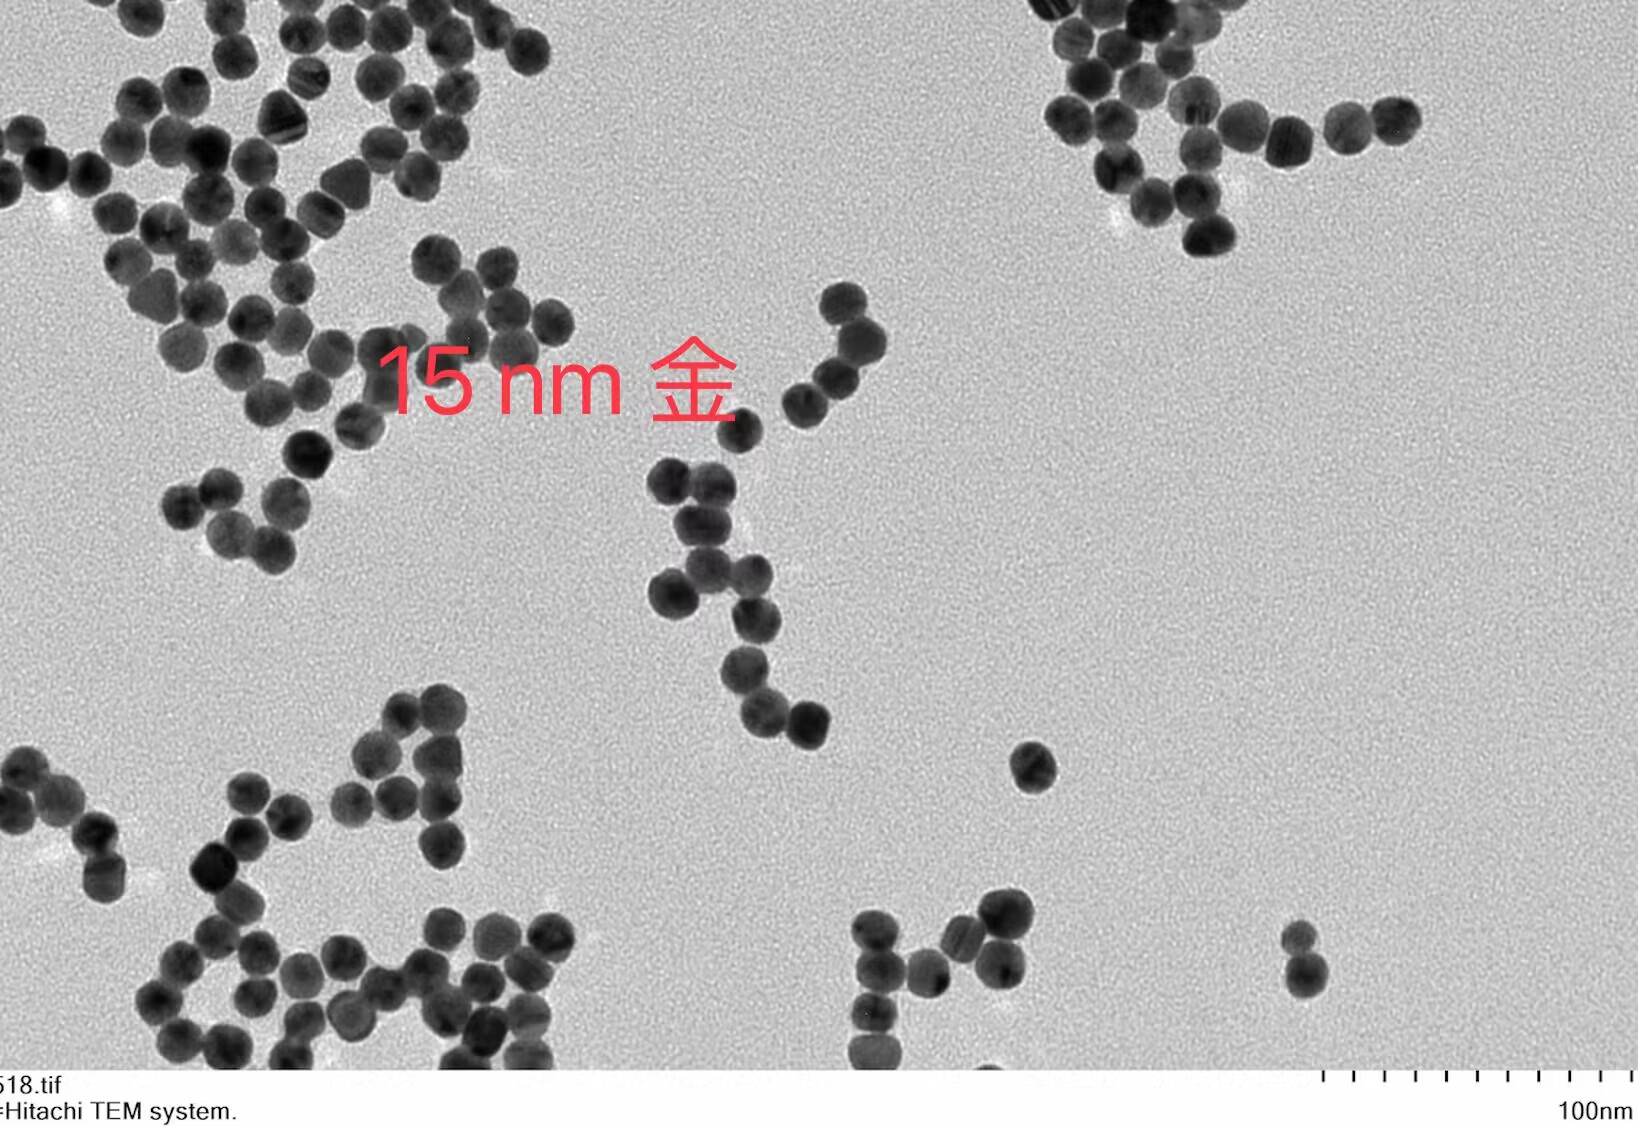

当前分类
THE CURRENT
CLASSIFICATION
-

金纳米颗粒
1.Citric acid Gold Nanoparticles
2.Tannic Acid Gold Nanoparticles¥ 0.00立即购买
-

基团修饰金纳米颗粒
1.PEG Gold Nanoparticles
2.PVP Gold Nanoparticles
3.Oil Gold Nanoparticles
4.PEI Gold Nanoparticles¥ 0.00立即购买
-

包覆金纳米颗粒
¥ 0.00立即购买
-

金纳米颗粒-蛋白/抗体
1.Protein A Gold Nanoparticles
2.Protein G Gold Nanoparticles
3.Transferrin Gold Nanoparticles
4.Streptavidin Gold Nanoparticles
5.Biotin Gold Nanoparticles
6.Antibody Conjugated Gold Nanoparticles¥ 0.00立即购买
-

荧光标记金纳米颗粒
¥ 0.00立即购买
-

金纳米棒
1.CTAB Gold Nanorods¥ 0.00立即购买